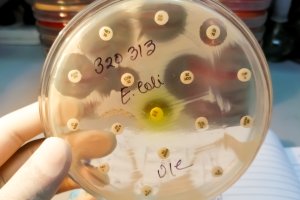
Woda do picia tylko po przegotowaniu. Sanepid ostrzega mieszkańców jednej z gmin

Dwa miesiące bez wody. Mieszkańcy gminy Grunwald mają dość
Ponad dwa tysiące mieszkańców gminy Grunwald nie może korzystać z wody lokalnego wodociągu. – Wody nie mamy już ze dwa miesiące – komentują mieszkańcy. O tym dlaczego trwa to tak długo opowiemy dziś w audycji Śliska Sprawa o 17.15.
Zakaz korzystania z wody w lokalnym wodociągu wydały służby sanitarne, po tym jak wykryto w nim bakterie Escherichia coli. Wody z kranu nie można pić, gotować w niej i używać do mycia.
Dobrze, że nie mamy małych dzieci. To porażka, ile to może trwać? Woda może się skazić wszędzie, ale nie tak długo. To trwa już ze dwa miesiące
– komentują mieszkańcy.
Posłuchaj audycji Wojciecha Chromego i Leszka Tekielskiego
Autor: L. Tekielski